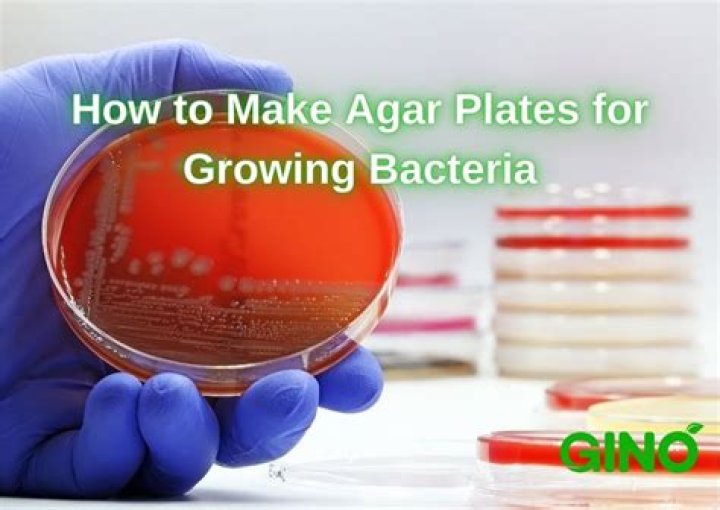

How is an agar plate made
We used sterile agar plates that provided the nutrients and correct pH for bacteria to grow. In this lab, you will be learning to produce these sterile agar plates. Agar is a polysaccharide derived from red algae. The agar powder is first dissolved in a boiling liquid, and then cooled to form a gelatinous solid matrix.
How do you make agar plates?
- Prepare a suitable work area. …
- Label the plates with the type of media you will pour into them.
- Swirl the hot media vigorously to mix.
- Cool the media until it is just cool enough to handle, about 20-30 minutes. …
- Swirl the media again to mix just before pouring; be careful not to incorporate bubbles.
How do you make agar for Petri dishes?
Mix 1 level teaspoon of dehydrated agar with 100 ml (3/8 cup) of room-temperature water. Bring to a boil while stirring to ensure the agar is completely dissolved. Pour 10-12 ml of hot agar into each petri dish, just covering the bottom. Replace the dish top immediately after pouring to prevent contamination.
What is agar and how is it made?
Agar (agar agar) is a gelatinous substance that is extracted from seaweed and processed into flakes, powders and sheets. It is commonly used in Asian cuisines and as a flavorless vegan substitute for gelatin.How is media prepared in microbiology?
Suspend 15 g of nutrient agar in 100 cm³ distilled water. Bring to the boil to dissolve completely. Heat 40 g of soluble starch in 100 cm³ of distilled water to form a suspension. Allow to cool and then mix with the nutrient agar solution.
What is source of agar?
Most agar is extracted from species of Gelidium (Figure 1) and Gracilaria (Figure 2). Closely related to Gelidium are species of Pterocladia, and small quantities of these are collected, mainly in the Azores (Portugal) and New Zealand. Gelidiella acerosa is the main source of agar in India.
How do you make agar plates for E coli?
Autoclave 15 g agar in 800 ml water for 15 min. Add sterile concentrated minimal medium and carbon source. After medium has cooled to about 50°C, add supplements and antibiotics. Pouring 32 to 40 ml medium into each plate, expect about 25 to 30 plates per liter.
How do I activate agar-agar?
Whether using agar agar in strips, flakes or powdered form, it is activated by being boiled in liquid for five minutes. By this point, the agar agar will have dissolved, and the liquid can be poured into moulds or ramekins, where it will set round 38-40°C.What is the difference between agar and gelatin?
Agar is a gelatinous substance that is originally made from seaweed. Gelatin is a colorless and odorless substance that is made from the collagen found inside animal bones and skin. Agar is used for conducting microbiological tests, as impression substance in dentistry, as a laxative and in electrochemistry.
How do you incubate agar plates at home?- Place each petri dish inside a zip lock bag to prevent drying out and to control odors.
- Turn the plates upside down and put them in a warm place. The ideal temperature for incubation is 32° C or 90° F. Bacterial growth should start to become visible in about 2 -3 days.
What are petri dishes made out of?
Petri dishes are shallow cylindrical containers with fitted lids that are designed specifically for microbiology or cell culture use. Petri dishes are typically made of borosilicate glass or clear plastics (usually polystyrene or polycarbonate) and come in a variety of sizes.
What is agar agar called in English?
noun. Also agar-agar. Also called Chinese gelatin, Chinese isinglass, Japanese gelatin, Japanese isinglass. a gelatinlike product of certain seaweeds, used for solidifying certain culture media, as a thickening agent for ice cream and other foods, as a substitute for gelatin, in adhesives, as an emulsifier, etc.
Why are agar plates stored upside down?
Petri dishes need to be incubated upside-down to lessen contamination risks from airborne particles landing on them and to prevent the accumulation of water condensation that could disturb or compromise a culture.
Why do you not seal agar plates completely?
Reason – The lid stops additional unwanted bacteria in the air contaminating the plate. Do not fully seal the lid, as this will stop oxygen reaching the bacterium, and this may encourage harmful anaerobic bacteria to grow.
How do you inject agar?
Using Agar: Remove lid of agar culture, using the scalpel remove a segment of colonised agar. Place agar in either the jar or bag of sterile media. Using Liquid Culture: Shake liquid culture syringe and inject 1 ml into the jar or bag via the injection port. Remove syringe, wipe down, flame sterilise and re-cap.
How culture media is prepared by?
Most commonly, culture media are based on a nutrient broth (liquid), often mixed with agar and prepared in petri dishes (they may be semi-solid or solid). For enriched or selective media, further specific components are added.
How is media prepared for tissue culture?
- Mix a powdered medium with the appropriate amount of water.
- If you are mixing for a 1-liter medium, then fill a beaker with 800ml distilled water. …
- Add 30g sucrose.
- Set the PH at 5.8.
- Add agar to the beaker (8g).
- Add hormone (if using).
How do you pour agar plates without condensation?
- • …
- • It is best to pour agar that is about 50º C. …
- • If you pour your own agar plates and get lots of bubbles, try gently passing the flame of a Bunsen. …
- • To prevent condensation of water in plates, let them solidify and dry at room temperature until the. …
- •
How can you tell if a plate is contaminated in agar?
Checking for Contamination Look for signs of fungal contamination. Fungal contamination will appear as fuzzy, filamentous, or hair-like growths, and should be visible to the unaided eye. Fungal contamination often occurs right along the edge of an agar plate.
Why is my agar bubbly?
If inverted too quickly, the formerly condensed air will expand and subsequently trap itself within the agar, hence the bubbles you’re seeing at the bottom. The bubbles are totally inconsequential unless you’re planning to use an optical plate reader, which may mistakenly interpret them as colonies.
How do you make agar plates with ampicillin?
Dissolve 15 g of Bacto agar in 1.0 L of LB medium and sterilize by autoclaving. Cool to 50°C in a temperature-controlled water bath. Add 0.50 mL of 100 mg/mL ampicillin. Pour into plates.
Does agar dissolve in water?
According to the US Pharmacopeia, agar can be defined as a hydrophilic colloid extracted from certain seaweeds of the Rhodophyceae class. It is insoluble in cold water but soluble in boiling water.
Can I replace agar agar with gelatin?
Agar is not a 1:1 substitute for gelatin. Victoria recommends using about half the amount of agar as a recipe with gelatin would call for, or about 1 teaspoon agar per 3 cups liquid.
Is konnyaku same as agar agar?
Agar Agar and Konnyaku are vegetarian substitute for Gelatin because they are made from a plant and have higher gelling properties. Agar Agar (Japan) is a gelatinous substance that is originally made from seaweed. … Konnyaku (Japan) produced from tubers of Konjac root.
Can you mix agar and gelatin?
Make sure to add the gelatin or agar agar to dry ingredients and whisk to combine well before mixing with any liquids. Both gelatin and agar agar can make gluten-free breads soggy, so be sure to measure carefully when using these gelling agents and don’t use more than a recipe calls for.
How long does it take agar to solidify?
*Pro-Tip* It takes roughly 30 min for our plates to solidify at room temperature, however we leave them out at room temperature overnight to allow them to dry. After overnight drying, we place the plates in a plastic bag with an absorbent material to reduce condensation.
What is the ratio of agar agar to liquid?
How to use agar agar. Use 2 tsp of agar flakes to every cup of liquid in a recipe. Like gelatin, it needs to be dissolved in liquid by bringing it to a boil over medium heat and then simmering until thickened, approximately five minutes.
Does agar need to be heated?
Agar must be heated to 85-90°C or it won’t melt, but make sure to not let it boil for too long past melting point as this can harm its gelling ability. … But unlike gelatin, agar can be re-melted if necessary, so don’t worry!
Can you make your own agar?
Add beef stock powder, sugar and gelatin to the boiling water and stir for a minute until all the ingredients have dissolved. Cool your new agar mixture slightly for 10 minutes. … Only take the lid off the petri dish when you are ready to pour your agar, or they will become contaminated with the bacteria in the air.



